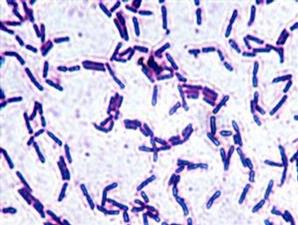

Death begins in the colon, demikian kalimat terkenal yang dilontarkan pemenang Nobel bidang Kedokteran tahun 1908, Elie Metchinikoff. Usus memegang peranan penting dalam pembuangan kotoran dan racun dari dalam tubuh, sekaligus berperan menyerap asupan nutrisi makanan.
Getty Images/Biodisc
Di dalam usus manusia terdapat 100 triliun mikroorganisme. Angka ini menakjubkan dibandingkan jumlah sel tubuh manusia dari ujung kaki sampai kepala yang hanya sekitar 50 triliun sel saja. Secara fisik, mikroorganisme terlihat sangat kecil. Namun, jangan salah. Keberadaan mikroorganisme di dalam usus memegang peran besar bagi kesehatan.Seperti diungkapkan Jimmy Hariantono PhD, ahli mikrobiologi dari PT Yakult Indonesia Persada, mikroorganisme yang sangat vital artnya bagi kekebalan tubuh. Mikroorganisme yang menghuni usus tidak semuanya baik, ada pula yang jahat. Bakteri baik dikenal sebagai spesies bakteri yang menguntungkan serta membantu fungsi pencernaan.
Jika tubuh kekurangan bakteri baik, maka akan mempengaruhi sistem kekebalan tubuh. Bila sudah demikian, maka tubuh menjadi rentan terserang penyakit, terutama akibat gangguan percernaan.
Untuk meningkatkan jumlah bakteri baik di dalam tubuh, dapat dilakukan dengan mengonsumsi prebiotik. Prebiotik merupakan makanan yang sesuai bagi bakteri baik, tapi tidak cocok untuk bakteri jahat. Prebiotik bisa didapatkan dari bahan makanan berserat yang mudah larut. Contoh sumber makanan alami prebiotik adalah gandum, bawang, pisang , bawang putih, madu, dan kacang-kacangan.
Keberadaan organisme jahat di dalam usus juga dapat dinetralisir secara alami lewat produk atau makanan yang mengandung bakteri probiotik. Bakteri probiotik ini salah satunya dapat diperoleh dari susu fermentasi.
"Yang diminum itu bukan susunya, melainkan bakteri baik yang berguna bagi usus dan tubuh manusia," kata Jimmy dalam acara coaching clinic di Jakarta, Selasa (28/8/2012).
Untuk meningkatkan jumlah bakteri baik di dalam tubuh, dapat dilakukan dengan mengonsumsi prebiotik. Prebiotik merupakan makanan yang sesuai bagi bakteri baik, tapi tidak cocok untuk bakteri jahat. Prebiotik bisa didapatkan dari bahan makanan berserat yang mudah larut. Contoh sumber makanan alami prebiotik adalah gandum, bawang, pisang , bawang putih, madu, dan kacang-kacangan.
Keberadaan organisme jahat di dalam usus juga dapat dinetralisir secara alami lewat produk atau makanan yang mengandung bakteri probiotik. Bakteri probiotik ini salah satunya dapat diperoleh dari susu fermentasi.
"Yang diminum itu bukan susunya, melainkan bakteri baik yang berguna bagi usus dan tubuh manusia," kata Jimmy dalam acara coaching clinic di Jakarta, Selasa (28/8/2012).

0 komentar:
Post a Comment